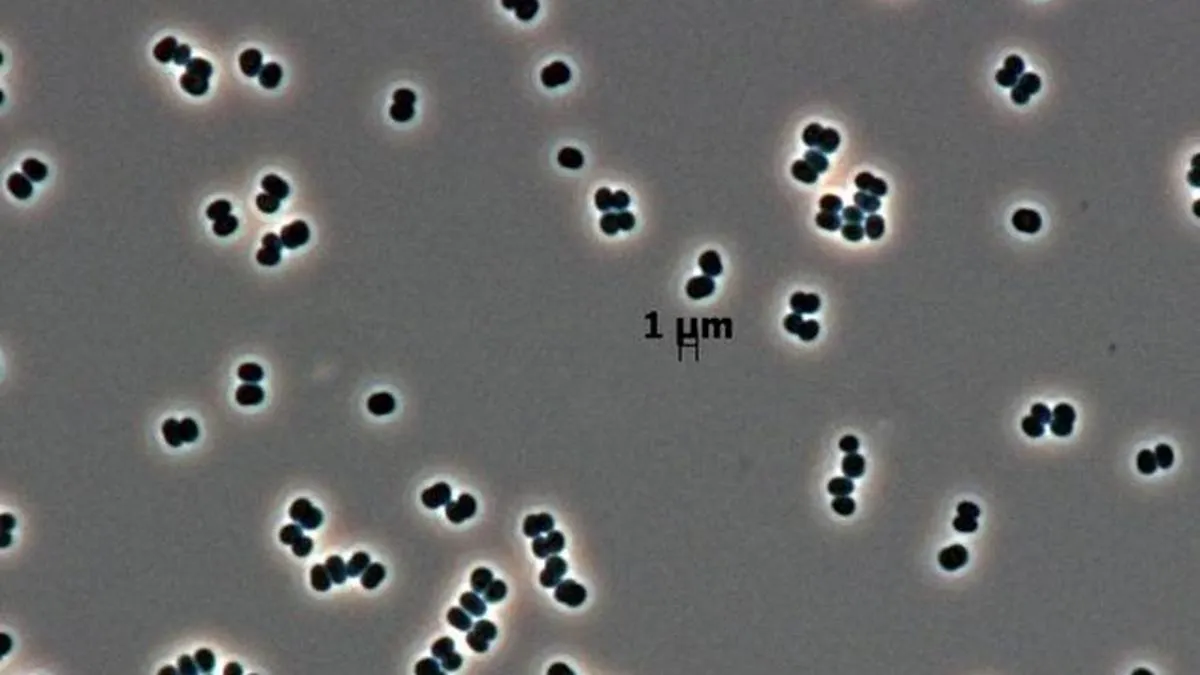
Zombie w laboratorium NASA. Bakterie, które przeraziły badaczy

Zombie w laboratorium NASA. Bakterie, które przeraziły badaczy
Nowe badania nad odkrytą przez NASA bakterią Tersicoccus phoenicis dowodzą, że mikrob ten potrafi przejść w stan skrajnego uśpienia, w zasadzie udawać martwego, aby przetrwać w najbardziej sterylnych środowiskach na Ziemi.
W miejscach, gdzie pojedynczy pyłek kurzu traktowany jest jak akt terroru, a powietrze jest czystsze niż w sali operacyjnej, wydarzyło się coś niemożliwego. W raporcie opublikowanym w czasopiśmie Microbiology Spectrum naukowcy szczegółowo opisali enigmatycznego Tersicoccus phoenicis, rzadki rodzaj bakterii występujący w najczystszych pomieszczeniach, w których montowane są statki kosmiczne, a który po raz pierwszy odkryto w obiektach NASA i Europejskiej Agencji Kosmicznej.
Najczystsze miejsca na Ziemi
Czyste pomieszczenie (częściej używa się angielskiego określenia clean room) to specjalnie zaprojektowana przestrzeń, w której ściśle kontroluje się warunki środowiskowe, takie jak stężenie cząstek, temperatura, wilgotność i ciśnienie, aby zminimalizować zanieczyszczenia. To tam montuje się najbardziej zaawansowane technologicznie urządzenia np. satelity.
Zapobieganie zanieczyszczeniom jest ważne, ponieważ pomaga zapewnić bezpieczeństwo misji kosmicznych, a jednocześnie gwarantuje, że wszelkie organizmy, które znajdziemy gdzie indziej w Układzie Słonecznym, będą obcym życiem, a nie bakteriami zawleczonymi tam przez nasze statki.

Nie będzie więc przesadą napisanie, że clean roomy to miejsca zaprojektowane tak, by zabić wszystko, co żywe. Sterylność jest tam na najwyższym poziomie. I to w takich miejscach naukowcy odkryli organizm, który nie tylko przetrwał, ale ewoluował, by oszukać nasze najlepsze systemy detekcji.
Wiadomo, że bakteria Tersicoccus phoenicis występuje tylko w dwóch miejscach na Ziemi i została niezależnie odkryta w pomieszczeniach czystych, oddalonych od siebie o niemal 4000 km.
Oszczędzanie baterii w bakterii
To, co robi Tersicoccus phoenicis, to biologiczny odpowiednik przejścia w tryb ultra-low power w twoim smartfonie, ale na skalę której do tej pory nie znaliśmy. Bakteria przechodzi w stan uśpienia w warunkach niedoboru składników odżywczych i wysuszenia.
Dzięki temu jest w stanie przetrwać w środowisku skrajnie nieprzyjaznym takim jak superczyste pomieszczenia NASA, a co gorsza, może przeżyć podróż przez próżnię kosmosu na poszyciu statku.
Najbardziej rzuciło mi się w oczy to, że Tersicoccus phoenicis nie tworzą przetrwalników. Sugeruje to, że u bakterii tej istnieją dodatkowe mechanizmy przetrwania, których jeszcze w pełni nie poznaliśmy – powiedział dr Nils Averesch, adiunkt w Katedrze Mikrobiologii i Nauki o Komórce Uniwersytetu Florydy.
Averesch zauważa, że clean roomy działają jak sito ewolucyjne, usuwają słabe jednostki, pozostawiając przy życiu tylko te organizmy, które potrafią przetrwać w najbardziej surowych warunkach. To klasyczny przykład niezamierzonych konsekwencji: im bardziej czyścimy, tym twardszych przeciwników selekcjonujemy.
Więcej na Spider's Web:
- Niespodziewane odkrycie w NASA. To nieznane wcześniej organizmy
- Przywróciliśmy do życia organizm sprzed 7 tys. lat. Niesamowity wyczyn naukowców badających Morze Bałtyckie
- Życie na Ziemi jest starsze, niż myśleliśmy. I od początku musiało walczyć ze śmiertelnym wrogiem
- Jeżeli powstanie taki organizm, to zagrozi życiu na Ziemi. Naukowcy z dramatycznym apelem
Bakteria Tersicoccus phoenicis potrafi pozostać nieaktywna nawet wtedy, gdy warunki wokół niej się poprawiają, co czyni ją mistrzem kamuflażu. Standardowe testy czystości, które szukają oznak aktywności biologicznej, mogą ją po prostu przeoczyć, uznając powierzchnię za sterylną, podczas gdy w rzeczywistości czai się na niej uśpiony pasażer.
To pokazuje, że niektóre mikroby mogą osiągać stany ultraniskiego metabolizmu, co pozwala im przetrwać w skrajnie surowych środowiskach. Fakt, że ta bakteria może celowo zawiesić swój metabolizm, sprawia, że przetrwanie na powierzchniach statków kosmicznych lub podczas podróży w głąb kosmosu jest bardziej prawdopodobne niż wcześniej zakładano – powiedział Averesch.
Teraz musimy uważać
Podkreślił on, że choć odkrycie te rodzą ważne pytania dotyczące ochrony innych planet, niekoniecznie oznaczają, że ziemskie mikroby mogłyby przetrwać np. na Marsie.
Jest mało prawdopodobne, by cokolwiek przetrwało wystawienie na bezpośrednie działanie czynników zewnętrznych na powierzchni Marsa. Ale w osłoniętych mikroniszach, pęknięciach podpowierzchniowych, porowatym regolicie lub pod skałami, przetrwanie życia jest bardziej prawdopodobne – powiedział naukowiec.



















